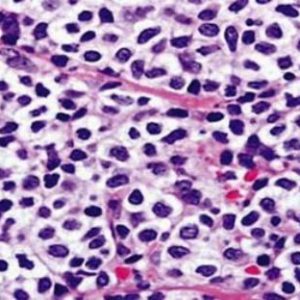
plazmocit2 plazmocit2

Шваннома – это опухоль из клеток нервной ткани, которые выполняют вспомогательную функцию (шванновские клетки). Также ее называют невриномой. Они создают миелиновую оболочку и дают возможность передавать нервные импульсы быстрее. Такая клеточная опухоль имеет доброкачественный характер, и может располагаться в разных областях нервной ткани, но чаще всего шваннома доброкачественная образуется около слухового нерва.
Невринома обычно развивается у женщин в среднем или старшем возрасте.
Симптомы
Сначала заболевание может никак не проявляться, но постепенно она начинает нарушать процесс кровообращение и нервная ткань не получает достаточно питательных веществ, а также сдавливается и приводит к серьезным осложнениям.
Симптомы заболевания зависят от того, в каком месте развивается новообразование. Если оно поражает лицевой нерв, больной будет страдать от шума в ушах, головокружений, нарушений мимики. Также со временем появятся признаки повышенного внутричерепного давления: тошнота, головная боль, нарушение зрительного восприятия, глотания, артикуляции.
При осмотре специалист заметит, что движения глазного яблока не соответствуют норме, отеки на лице, потерю чувствительности, слабость и т.п. В очень сложных случаях может начаться паралич или гидроцефалия.
Если шваннома развивается на позвоночнике, у человека будут проблемы в той области, за которую отвечает определенное место: могут начаться параличи, снижение чувствительности, парезы, а также сильные боли.
Шваннома представляет собой доброкачественную опухоль, возникающую из клеток Шванна, которые образуют миелиновую оболочку нервных волокон. Врачи отмечают, что данное образование чаще всего развивается на периферических нервах, хотя может встречаться и в других областях, включая спинной мозг. Симптоматика шванномы может варьироваться в зависимости от её локализации и размера. Часто пациенты жалуются на боли, онемение или слабость в области, иннервируемой поражённым нервом. Важно отметить, что шванномы обычно растут медленно и имеют низкий риск малигнизации. Однако, в случае значительного роста или компрессии окружающих тканей, может потребоваться хирургическое вмешательство. Врачи подчеркивают важность ранней диагностики и регулярного наблюдения, чтобы минимизировать возможные осложнения и улучшить качество жизни пациентов.

Виды шванномы
По внешнему виду она напоминает узел плотной структуры, который может иметь круглую или неправильную форму и бугристую поверхность. По цвету она может отличаться в зависимости от того, какое кровоснабжение получает этот участок нервов. Если начинается венозный застой, цвет будет синим и т.п. Обычно она находится в капсуле из соединительной ткани, поэтому ее можно без труда удалить.
По строению различают несколько видов образования:
- эпилептоидное (характерной особенностью является плотное расположение клеток опухоли и незначительное количество волокон);
- ангиоматозное (с множеством кавернозных полостей, которые возникают из-за того, что сосуды патологически расширяются);
- ксантоматозное (в таком образовании находят большое количество ксантохромных клеток, в которых есть много пигмента).
По месторасположению наиболее распространены: позвоночник, слуховой нерв, подошвенный нерв.
Шваннома слухового нерва, или вестибулярная, бывает у одного из ста, и представляет собой одно из наиболее распространенных опухолевых образований доброкачественной природы. Растет она от 1 до 2 мм в год, но иногда рост происходит очень быстро, при этом оказывается большое давление на мозжечок, ствол мозга и поражаются все лицевые нервы.
Она может быть одно- или двухсторонней.
Шваннома подошвенного нерва стопы также называет болезнью Мортона. Она растет в зоне между 3 и 4 пальцами, иногда может образоваться между 2 и 3. Обычно причина заключается в травме стопы из-за плоскостопия, внешнего повреждения, инфекций, переломов, неудобной обуви и т.п. из-за такого воздействия в области нерва может начаться утолщение, а при сдавливании костей и связок начинается воспаление. При этом процессе человек сначала чувствует онемение и боли, иногда жжение и покалывание.
При росте опухоли боли становятся сильнее.
При повреждении позвоночника она развивается в области оного. Оболочек периферического нерва, спинномозгового или черепного. Обычно развивается у женщин и не приобретает злокачественную форму. Она прогрессирует в корешках шейного и грудного отделов спинного мозга, иногда в поясничном отделе.
Развиваясь в зоне средостения, опухоль может мутировать и начинает развиваться злокачественная форма.
Клиника диагностика лечение
Лечение назначается в зависимости от того, где растет шваннома, как быстро развивается и других факторов. Чаще всего проводиться удаление шванномы. На ранней стадии ее можно провести малоинвазивными методами, которые позволяют сохранить слух.
Есть радиологический метод лечения, который обычно назначается пожилым людям, если они не хотят ложиться на операцию. Проведение возможно, если размер не больше 3 см.
Есть и консервативные методы лечения. Таким больным назначают диуретики, глюкокортикоиды, а также лекарства, которые улучшают мозговое кровообращение.
В случае злокачественной формы также проводится операция.
Шваннома — это доброкачественная опухоль, возникающая из клеток шванновой оболочки, которые окружают нервы. Многие люди, узнав о диагнозе, испытывают страх и неуверенность. Некоторые отмечают, что шванномы могут проявляться различными симптомами, такими как боли, онемение или слабость в конечностях, что заставляет их обращаться к врачам. Важно, что большинство шванном не требует немедленного лечения, и многие пациенты живут с ними долгое время без значительных проблем. Однако для других необходимость в хирургическом вмешательстве становится актуальной, что вызывает множество вопросов о рисках и последствиях. Обсуждая шванномы, люди часто делятся своим опытом, что помогает создать сообщество поддержки и понимания.

Нужна ли после удаления шванномы лучевая терапия?
Лучевая терапия при злокачественной шванноме иногда применяется как дополнительное средство, чтобы избежать рецидива, а также в тех случаях, когда удаление невозможно.
Предлагаемые народные средства лечения злокачественной шванномы не доказали на практике свою эффективность. Поэтому при проявлении первых симптомов, нужно сразу обратиться к профессиональному врачу.
Вопрос-ответ

Каковы основные симптомы шванномы?
Симптомы шванномы могут варьироваться в зависимости от ее расположения. Обычно пациенты испытывают боль, онемение или слабость в области, где находится опухоль. Если шваннома сдавливает нервы, это может привести к нарушению чувствительности или функции конечностей.
Как диагностируется шваннома?
Диагностика шванномы обычно включает физический осмотр, а также визуализирующие исследования, такие как МРТ или КТ, которые помогают определить размер и расположение опухоли. В некоторых случаях может потребоваться биопсия для подтверждения диагноза.
Каковы методы лечения шванномы?
Лечение шванномы зависит от ее размера, расположения и симптомов. В большинстве случаев рекомендуется хирургическое удаление опухоли. В некоторых случаях, особенно если опухоль не вызывает симптомов, может быть предложено наблюдение без активного вмешательства.
Советы
СОВЕТ №1
Перед посещением врача подготовьте список симптомов и вопросов, которые вас беспокоят. Это поможет вам более эффективно обсудить свое состояние и получить необходимую информацию о шванномах.
СОВЕТ №2
Изучите информацию о шванномах и их возможных последствиях. Знание о заболевании поможет вам лучше понять процесс диагностики и лечения, а также снизит уровень тревожности.
СОВЕТ №3
Обсудите с врачом все доступные варианты лечения и их возможные побочные эффекты. Это поможет вам принять обоснованное решение о том, какой подход будет наиболее подходящим для вашей ситуации.
СОВЕТ №4
Не стесняйтесь обращаться за поддержкой к близким или группам поддержки. Общение с людьми, которые сталкивались с подобными проблемами, может оказать значительное эмоциональное воздействие и помочь вам справиться с ситуацией.